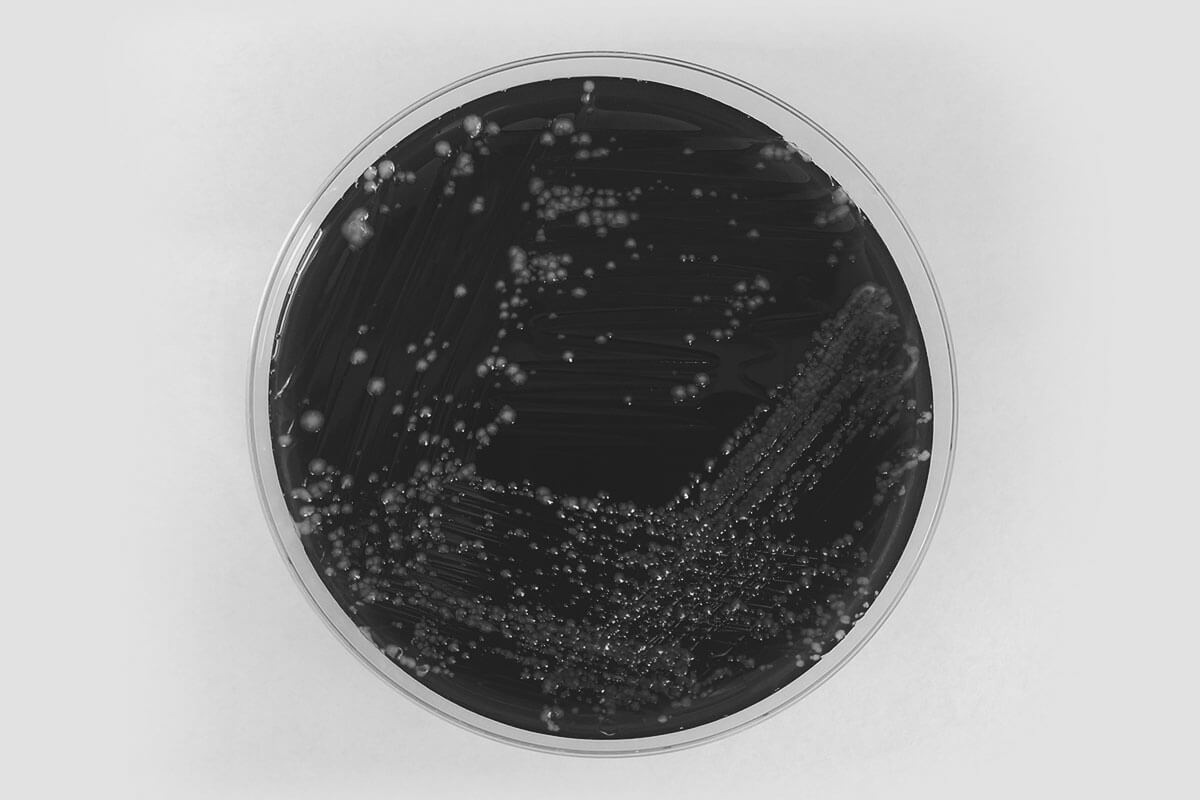

Kühlwasser
Service Pakete
VDI 2047-2 sieht regelmäßige Hygienekontrollen relevanter Anlagenteile und physikalisch chemische Untersuchungen vor. Diese Untersuchungen gehen weiter als die nach 42. BlmSchV vorgesehenen 14-tägigen Prüfungen chemischer, physikalischer oder mikrobiologischer Parameter.


Konzentrationen an Konditionierungsmitteln, korrosionsrelevante Parameter, ablagerungsrelevante Parameter sowie Stoffe die das mikrobiologische Wachstum fördern können, müssen geprüft und auf ihre Relevanz bewertet werden. Anlagenkomponenten müssen auf ihren Zustand und ihre verlässliche Funktion überprüft werden, die Ergebnisse sind zu dokumentieren.
Verbrauchserfassungen geben ferner Aufschluss auf korrekte Dosierungen und Funktionen von Dosier- und Regelanlager.
Gemeinsam mit Ihnen stelle ich das für Ihren Betrieb sinnvolle Konzept zusammen und führe die notwendigen Prüfungen durch. Durch Einbindung Ihrer Mitarbeiter können Sie langfristig ihre eigenes KnowHow vertiefen und Teilbereiche mit eigenem Personal abdecken.

Auch die regelmäßige Legionellen Probenahme für die Untersuchung in einem akkreditierten Labor führe ich durch.
Hierbei handelt es sich nicht um Sachverständigenleistungen aus dem Bereich der öffentlichen Bestellung und Vereidigung. An Anlagen, für die ich diese Serviceleistungen erbracht habe, kann ich auf Grund der gebotenen Neutralität und Unbefangenheit keine Sachverständigenprüfung nach §14, 42. BlmSchV durchführen!